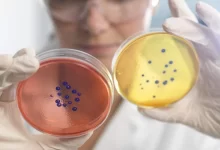

Türkiyədə təhsil
Dekabr 18, 2025
Türkiyədə Doktorantura Təhsili: Qəbul şərtləri, Təhsil haqqı
Doktorantura təhsili akademik inkişafın ən yüksək mərhələlərindən biri hesab olunur və elmi tədqiqat bacarıqlarının dərinləşdirilməsində…
Türkiyədə təhsil
Dekabr 17, 2025
Türkiyədə Bakalavr Təhsili: Tələbə Həyatı,Sosial İnkişaf
Türkiyə, son illərdə beynəlxalq tələbələr üçün cəlbedici təhsil məkanı olaraq diqqəti cəlb edir. Ölkənin universitetləri…
Türkiyədə təhsil
Dekabr 17, 2025
Türkiyə Universitetləri: Təhsil Sistemi,Akademik Struktur
Türkiyə, son illərdə beynəlxalq tələbələr üçün cəlbedici təhsil məkanı kimi ön plana çıxır. Ölkənin universitetləri…
Ukraynada Təhsil
Dekabr 17, 2025
Ukrayna Universitetləri: Məşhur Universitetlər, İxtisaslar
Ukrayna son illərdə beynəlxalq tələbələr üçün cəlbedici təhsil məkanı kimi ön plana çıxıb. Ölkənin universitetləri…
Xarici Univerisitetlər
Dekabr 17, 2025
Xaricdə Təhsil: Tələbə Həyatı, Sosial İnkişaf
Xaricdə təhsil, gənclərə yalnız akademik bilik qazandırmaqla kifayətlənmir, eyni zamanda fərdi, sosial və peşəkar inkişaf…
Təhsil
Dekabr 17, 2025
Türkiyədə Təhsil: Təhsil Haqqları, Tələbə Həyatı
Türkiyə, yalnız turizm və mədəniyyət mərkəzi kimi deyil, həm də ali təhsil üçün unikal ölkədir.…
Universitet
Sentyabr 1, 2025
Kutafin adına Moskva Dövlət Hüquq Universiteti : Qəbul şərtləri, Fakültələr
Kutafin adına Moskva Dövlət Hüquq Universiteti (MSAL) müasir Rusiyanın ən nüfuzlu və tanınmış hüquq təhsil…
Rusiyada Təhsil
Sentyabr 1, 2025
Beynəlxalq Fundamental Tədqiqatlar Universiteti : Qəbul qaydaları, Fəaliyyəti
Beynəlxalq Fundamental Tədqiqatlar Universiteti elm və təhsilin sərhədlərini genişləndirən, qlobal miqyasda elmi-tədqiqat işlərinin və elmi…
Rusiyada Təhsil
Sentyabr 1, 2025
Moskva Beynəlxalq Universiteti : Akademik Strukturu, Fəaliyyəti
Moskva Beynəlxalq Universiteti müasir dövrün elmi, iqtisadi və sosial çağırışlarına cavab verən, çoxprofilli və beynəlxalq…
Rusiyada Təhsil
Sentyabr 1, 2025
Beynəlxalq İqtisadiyyat və Hüquq İnstitutu : Tədris proqramları, Qəbul qaydaları
Beynəlxalq İqtisadiyyat və Hüquq İnstitutu müasir Rusiyanın ali təhsil sistemində xüsusi yeri olan, hüquq, iqtisadiyyat,…